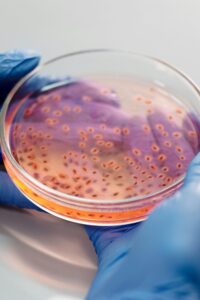
yeni bir pandemi, mantar enfeksiyonları, antifungal direnci,

Yeni bir pandemi mantar enfeksiyonlarıyla mı gelecek?

Yeni bir pandemi tehlikesi mantar enfeksiyonlarıyla gelebilir. Uzmanlara göre tarımda ve tıpta kontrolsüz antifungal kullanımı, mantarların direnç kazanmasına ve ölümcül enfeksiyonların artmasına yol açıyor.
Mantar enfeksiyonları dünya genelinde hızlı bir yükselişe geçti. Kaliforniya Üniversitesi Davis’ten enfeksiyon hastalıkları uzmanları Dr. George Thompson ve Dr. Angel Desai, bu tehlikenin küresel sağlık sistemi üzerinde yıkıcı etkiler yaratabileceği konusunda uyarıyor. New England Journal of Medicine’da yayımladıkları makalede, antifungal ilaçlara karşı gelişen dirençle birlikte “yeni bir pandemi” riskinin ortaya çıktığını belirtiyorlar.
Antifungal Direnci: Sessiz Tehlike
Antifungal Direnci: Sessiz Tehlike
Tarımda ve sağlık sektöründe yaygın şekilde kullanılan antifungal (mantar karşıtı) ilaçlar, kontrolsüz ve bilinçsiz uygulamalarla bazı mantar türlerinin direnç geliştirmesine neden oluyor. Bu direnç, mantarların tedaviye yanıt vermemesiyle sonuçlanıyor ve özellikle bağışıklık sistemi zayıf bireylerde ölümcül enfeksiyonlara yol açabiliyor.
Dr. Thompson, “Antibiyotik direncinde gördüğümüz tehlikeleri şimdi antifungal ajanlarda da yaşamaya başladık. Bu, sadece insan sağlığını değil; tarımı, hayvancılığı ve çevreyi de tehdit eden çok yönlü bir krizdir,” diyerek küresel çapta önlem alınması gerektiğini vurguluyor.
“Tek Sağlık” Yaklaşımı Şart
Uzmanlar, mantar enfeksiyonlarıyla mücadelede “tek sağlık” (One Health) yaklaşımının benimsenmesi gerektiğini savunuyor. Bu yaklaşım, insan, hayvan ve çevre sağlığının birbirine bağlı olduğunu kabul ederek, bütünsel çözümler sunmayı amaçlıyor.
Dr. Desai, “Tarımda kullanılan antifungaller, çevre aracılığıyla insanlara da ulaşıyor. Bu nedenle sağlık politikaları yalnızca klinikleri değil, tarım ve çevre uygulamalarını da kapsamalı,” diyor.
İklim Değişikliği ve Seyahatler Yayılmayı Hızlandırıyor
İklim değişikliği, hava hareketleri ve artan uluslararası seyahat, mantar enfeksiyonlarının yayılmasını kolaylaştırıyor. Seyahat eden insanlar, göçmen hayvanlar ve kontamine olmuş nesneler, dirençli patojenlerin farklı coğrafyalara taşınmasına neden olabiliyor.
Bu durum, hastanelerde ve yoğun bakım ünitelerinde zaten risk altında olan bireyler için ciddi sonuçlar doğurabiliyor.
Candida Auris: Tehlikenin Somut Örneği
Son yıllarda adını sıkça duyuran Candida auris, antifungal ilaçlara karşı dirençli ve tedavisi son derece zor bir mantar türü olarak öne çıkıyor. İnsan hücrelerine benzer yapısı nedeniyle tedavi sürecinde kullanılan ilaçlar ciddi yan etkilere yol açabiliyor.
En büyük sorunlardan biri ise; bu türlere karşı etkili antifungal seçeneklerin sınırlı olması. Direnç geliştikçe, etkili tedavi seçenekleri daha da azalıyor.
Küresel Koordinasyon Çağrısı
Thompson ve Desai, antifungal direncin doğrudan kullanılan ilaç miktarıyla ilişkili olduğunu belirterek, tarım ilaçlarının geliştirilmesi ve kullanımının küresel düzeyde denetlenmesi gerektiğini söylüyor.
“Ulusal ve uluslararası kurumlar arasında ortak karar alma süreçleri oluşturulmalı. Bu koordinasyon, dirençli patojenlerin yayılmasını yavaşlatabilir ve sağlık sistemlerine binen yükü azaltabilir,” uyarısında bulunuyorlar.
Yeni Pandemi Riski: 24 Tehlikeli Patojen Grubu Belirlendi – Editörün Gözünden
Erken Önlem Alınmazsa Yeni Bir Pandemi Kaçınılmaz Olabilir
Mantar enfeksiyonları sessizce yayılırken, bilim insanları bu tehdidin göz ardı edilmemesi gerektiği konusunda hemfikir. Antifungal ilaçlara karşı gelişen direnç, tedavi edilemeyen hastalıklara yol açabilir ve bu durum, COVID-19 benzeri yeni bir pandemiye zemin hazırlayabilir. Uzmanlar, mantarlarla mücadelede bilinçli ilaç kullanımı, çevresel denetim ve küresel iş birliğinin hayati önemde olduğunu vurguluyor.






